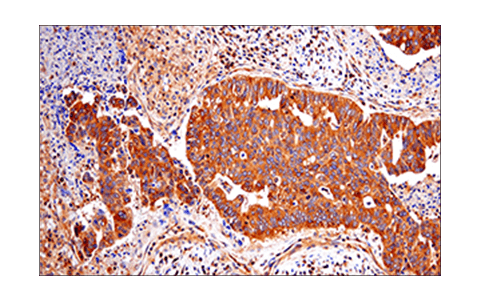
undefined Image 23: Apoptosis/Necroptosis Antibody Sampler Kit II

Revision 1
#73966
Store at -20C
Apoptosis/Necroptosis Antibody Sampler Kit II
1 Kit
(8 x 20 microliters)
877-616-CELL (2355)
877-678-TECH (8324)
3 Trask Lane | Danvers | Massachusetts | 01923 | USA
For Research Use Only. Not for Use in Diagnostic Procedures.
| Product Includes | Product # | Quantity | Mol. Wt | Isotype/Source |
|---|---|---|---|---|
| RIP (E8S7U) Rabbit Monoclonal Antibody | 73271 | 20 µl | 78 kDa | Rabbit IgG |
| Phospho-RIP (Ser166) (D1L3S) Rabbit Monoclonal Antibody | 65746 | 20 µl | 78-82 kDa | Rabbit IgG |
| RIP3 (E7A7F) Rabbit Monoclonal Antibody | 10188 | 20 µl | 46-62 kDa | Rabbit IgG |
| Phospho-RIP3 (Ser227) (D6W2T) Rabbit Monoclonal Antibody | 93654 | 20 µl | 46-62 kDa | Rabbit IgG |
| MLKL (E7V4W) Mouse Monoclonal Antibody | 26539 | 20 µl | 54 kDa | Mouse IgG2b kappa |
| Phospho-MLKL (Ser358) (D6H3V) Rabbit Monoclonal Antibody | 91689 | 20 µl | 54 kDa | Rabbit IgG |
| Cleaved Caspase-8 (Asp374) (E6H8S) Rabbit Monoclonal Antibody | 98134 | 20 µl | 18, 41, 43 kDa | Rabbit IgG |
| Cleaved Caspase-3 (Asp175) (5A1E) Rabbit Monoclonal Antibody | 9664 | 20 µl | 17, 19 kDa | Rabbit IgG |
| Anti-rabbit IgG, HRP-linked Antibody | 7074 | 100 µl | Goat | |
| Anti-mouse IgG, HRP-linked Antibody | 7076 | 100 µl | Horse |
Please visit cellsignal.com for individual component applications, species cross-reactivity, dilutions, protocols, and additional product information.
Description
Storage
Background
Necroptosis, a regulated pathway for necrotic cell death, is triggered by a number of inflammatory signals, including cytokines in the tumor necrosis factor (TNF) family, pathogen sensors such as toll-like receptors (TLRs), and ischemic injury (3,4). Necroptosis is negatively regulated by caspase-8 mediated apoptosis in which the kinase RIP/RIPK1 is cleaved (5). Furthermore, necroptosis is inhibited by a small molecule inhibitor of RIP, necrostatin-1 (Nec-1) (6). Research studies show that necroptosis contributes to a number of pathological conditions, and Nec-1 has been shown to provide neuroprotection in models such as ischemic brain injury (7). RIP is phosphorylated at several sites within the kinase domain that are sensitive to Nec-1, including Ser14, Ser15, Ser161, and Ser166 (8). Phosphorylation drives association with RIP3, which is required for necroptosis (9-11). Mixed lineage kinase domain-like protein (MLKL) is a pseudokinase that was identified as a downstream target of RIP3 in the necroptosis pathway (12). During necroptosis, RIP3 is phosphorylated at Ser227, which recruits MLKL and leads to its phosphorylation at Thr357 and Ser358 (12). Knockdown of MLKL through multiple mechanisms results in inhibition of necroptosis (13). Phosphorylation of MLKL during necroptosis leads to its oligomerization with pore formation that affects membrane integrity (14-17).
Background References
- Degterev, A. et al. (2003) Oncogene 22, 8543-67.
- Green, D.R. (1998) Cell 94, 695-8.
- Christofferson, D.E. and Yuan, J. (2010) Curr Opin Cell Biol 22, 263-8.
- Kaczmarek, A. et al. (2013) Immunity 38, 209-23.
- Lin, Y. et al. (1999) Genes Dev 13, 2514-26.
- Degterev, A. et al. (2008) Nat Chem Biol 4, 313-21.
- Degterev, A. et al. (2005) Nat Chem Biol 1, 112-9.
- Ofengeim, D. and Yuan, J. (2013) Nat Rev Mol Cell Biol 14, 727-36.
- Cho, Y.S. et al. (2009) Cell 137, 1112-23.
- He, S. et al. (2009) Cell 137, 1100-11.
- Zhang, D.W. et al. (2009) Science 325, 332-6.
- Sun, L. et al. (2012) Cell 148, 213-27.
- Wu, J. et al. (2013) Cell Res 23, 994-1006.
- Cai, Z. et al. (2014) Nat Cell Biol 16, 55-65.
- Chen, X. et al. (2014) Cell Res 24, 105-21.
- Wang, H. et al. (2014) Mol Cell 54, 133-46.
- Dondelinger, Y. et al. (2014) Cell Rep 7, 971-81.
Trademarks and Patents
Cell Signaling Technology is a trademark of Cell Signaling Technology, Inc.
All other trademarks are the property of their respective owners. Visit cellsignal.com/trademarks for more information.
Limited Uses
Except as otherwise expressly agreed in a writing signed by a legally authorized representative of CST, the following terms apply to Products provided by CST, its affiliates or its distributors. Any Customer's terms and conditions that are in addition to, or different from, those contained herein, unless separately accepted in writing by a legally authorized representative of CST, are rejected and are of no force or effect.
Products are labeled with For Research Use Only or a similar labeling statement and have not been approved, cleared, or licensed by the FDA or other regulatory foreign or domestic entity, for any purpose. Customer shall not use any Product for any diagnostic or therapeutic purpose, or otherwise in any manner that conflicts with its labeling statement. Products sold or licensed by CST are provided for Customer as the end-user and solely for research and development uses. Any use of Product for diagnostic, prophylactic or therapeutic purposes, or any purchase of Product for resale (alone or as a component) or other commercial purpose, requires a separate license from CST. Customer shall (a) not sell, license, loan, donate or otherwise transfer or make available any Product to any third party, whether alone or in combination with other materials, or use the Products to manufacture any commercial products, (b) not copy, modify, reverse engineer, decompile, disassemble or otherwise attempt to discover the underlying structure or technology of the Products, or use the Products for the purpose of developing any products or services that would compete with CST products or services, (c) not alter or remove from the Products any trademarks, trade names, logos, patent or copyright notices or markings, (d) use the Products solely in accordance with CST Product Terms of Sale and any applicable documentation, and (e) comply with any license, terms of service or similar agreement with respect to any third party products or services used by Customer in connection with the Products.
Revision 1



Revision 1



Revision 1



Revision 1



Revision 1



Revision 1



Revision 1

Revision 1



Revision 1



Revision 1



Revision 1



Revision 1



Revision 1



Revision 1



Revision 1



Revision 1



Revision 1



Revision 1

